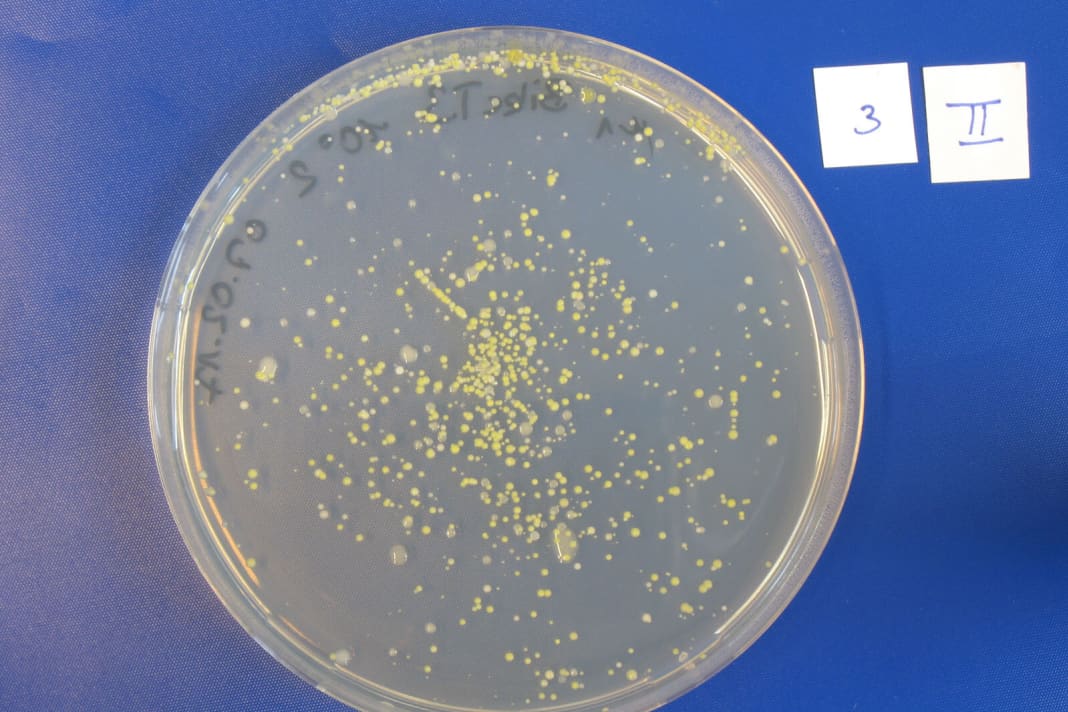
Auf sogenannten Agar-Platten ist ein Nährmedium aufgebracht. Davon ernähren sich die Bakterien und wachsen dann in Kolonien heran (gelbe Punkte).
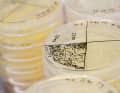
Nach zwei Tagen im Brutschrank werden die Bakterien-Kolonien ausgezählt. Wie man sieht, ist ordentlich was gewachsen.
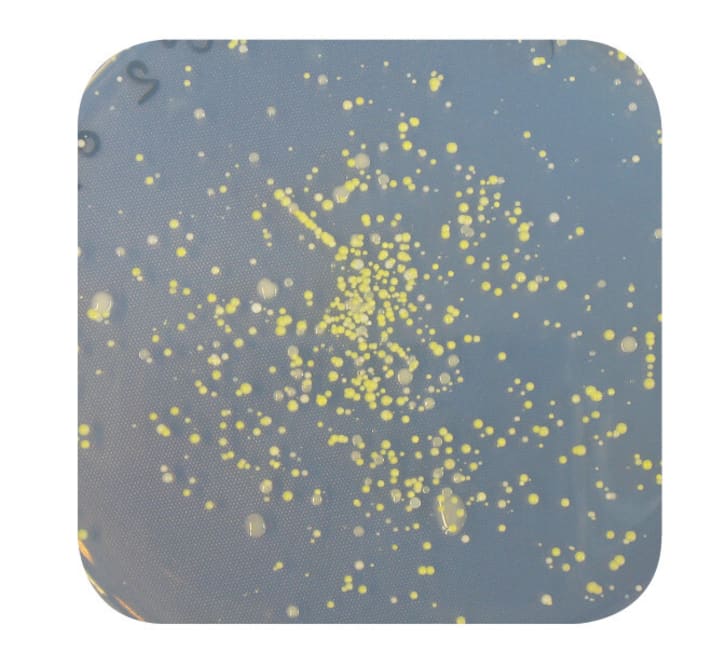
Bakterien auf einem Polyester-Shirt

Erkenntnisse aus unseren Labortests: Das hilft gegen stinkende Sportbekleidung
Stefan Frey
· 24.07.2023

In diesem Artikel verwenden wir sogenannte Affiliate Links. Bei jedem Einkauf über diese Links erhalten wir eine Provision vom Händler. Alle vermittlungsrelevanten Links sind mit gekennzeichnet. Mehr erfahren.
Silberionen, Merinowollfasern, Waschzusätze und altbewährte Hausmittel – die Klamottenindustrie kennt viele Wege, unangenehme Gerüche in Sportbekleidung zu entschärfen. Doch was wirkt wirklich und woher kommt der beißende Geruch in getragenen Bike-Shirts und Unterhemden eigentlich?
Das lesen Sie im Artikel:
Um dem rätselhaften Schweißgeruch auf die Schliche zu kommen, haben wir aufwändige Labortests durchgeführt. Die Experten des Mikrobiologie-Spezialisten Vermicon standen uns dabei mit Rat und Tat zur Seite. Die Grunderkenntnis unseres Versuchs: frischer Schweiß stinkt nicht. Schuld für den Gestank sind Bakterien, die natürlich auf der menschlichen Haut vorkommen. Genauer gesagt sind es zwei Vertreter der Arten Firmicutes und Actinobacteria. Sie verstoffwechseln die Schweißmoleküle in der Fahrradbekleidung und scheiden dann stinkende Gase aus.

Sportbekleidung: die Schweißkiller Merino & Co. im Test
Für unseren Test waren wir auf der Suche nach Materialien und Mitteln, die die Geruchsbildung verhindern sollen. Unterwäsche mit Silberionen gehören seit vielen Jahren zu den populärsten Geruchshemmern bei Sportbekleidung auf dem Markt. Die antimikrobielle Ausrüstung soll die Zellstruktur der Bakterien verändern und so ihr Wachstum unterbinden. Das natürliche Pendant dazu: Merinowolle. Der Wolle des Merinoschafes haftet der Ruf an, geruchshemmend zu wirken. Über die genaue Wirkungsweise ist bisher jedoch nur wenig bekannt.
Um herauszufinden, ob die Produkte wirklich so funktionieren wie die Hersteller versprechen, haben wir uns jeweils zwei Exemplare eines Silber- und eines Merino-Shirts besorgt. Je ein Unterhemd wurde fabrikneu getragen und dann ins Labor geschickt, die anderen beiden wurden zuerst zehnmal gewaschen, dann getragen und anschließend zur Untersuchung gebracht. Wir wollten natürlich auch wissen, wie haltbar die Anti-Stink-Effekte sind.
In einem weiteren Versuch wurde ein klassisches Polyester-Shirt getragen und an das Labor verschickt. Aus diesem Shirt wurden Proben entnommen und anschließend unterschiedlich behandelt. Überprüft wurde, wie rückstandslos Sportwaschmittel, Hygienespüler und Waschsoda (Natron) die Bakterien – somit die Quelle des Gestanks – aus der Wäsche entfernen. Zusätzlich haben wir mit der “Gefrierschrank-Methode” einen alten Haushaltsmythos unter die Lupe genommen – mit einem überraschenden Ergebnis.




Bakterien-Analyse unter dem Mikroskop
Bei der Untersuchung der Proben auf Geruchs-Bakterien setzen die Experten von Vermicon auf eine einzigartige Technologie – VIT Gensondentechnologie genannt. Den Proben der Fahrradbekleidung werden über eine Lösung Gensonden zugegeben. Diese Gensonden bestehen aus einem RNA-Strang, dem ein Farbstoff angehängt wird. Die Gensonden dringen in die Bakterien ein und heften sich, nach dem Schlüssel-Schloss-Prinzip, an die RNA der Bakterien. Das klappt natürlich nur, wenn die Gensonde zur RNA der Bakterien passt. Nun sind die Farbstoff-Moleküle in der Bakterienzelle eingeschlossen. Legt man die Proben dann unter das Mikroskop, beginnen die Zellen zu leuchten. So lassen sich Firmicutes oder Actinobakterien in den Stoffen gezielt nachweisen.

Um zu ermitteln, wie viele Bakterien in den Proben wachsen, werden die Geruchserreger aus den Shirts gelöst und eine definierte Menge auf einen Nährboden aufgetragen. Nach zwei Tagen bei 37 Grad im Brutschrank werden die Bakterienkolonien auf dem Nährmedium ausgezählt. Über diese beiden Methoden lässt sich eine eindeutige Aussage über das Vorhandensein von Bakterien treffen.

Nach dem Laborversuch bestellt uns Claudia Beimfohr zur Auswertung ein. Das Ergebnis überrascht sogar die Forscherin: Auf den Proben der beiden fabrikneuen Shirts drängeln sich die Bakterienkolonien wie Groupies auf einem Pop-Konzert. Eine Auszählung ist kaum noch möglich. Allein von der sportlichen Betätigung kann das nicht kommen, rätselt die Expertin. Ihre Vermutung: Schon bei Produktion, Verpackung und Transport könnten die Funktions-Shirts in Kontakt mit Bakterien kommen. Auch wenn es sich dabei um ungefährliche Arten handelt, rät Beimfohr ausdrücklich dazu, ein neues Teil vor dem ersten Tragen einmal gründlich zu waschen. Ein anderes Bild zeigt sich auf den Nährmedien der zehnmal gewaschenen Shirts. Die Bakterienzahlen gleichen eher dem Bild der Amtseinführung des neuen amerikanischen Präsidenten vor dem Kapitol. Es ist noch relativ viel Platz frei in den Schälchen. Das Ergebnis verstärkt unsere erste These, wirft aber weitere Fragen auf. Warum wachsen auf dem Shirt mit der Silberausrüstung noch immer deutlich nachweisbare Kolonien der Stinke-Bakterien? Eigentlich sollten sich die Mikroben nach dem Silberkontakt doch nicht mehr weiter vermehren, verspricht zumindest der Hersteller.
Die größten Stinker: Diese Bakterien sorgen für unangenehme Gerüche in der Fahrradbekleidung
Schweiß an sich ist geruchsneutral. Für den Gestank in der Fahrradbekleidung sind Bakterien zuständig. Zwei Exemplare konnten wir als maßgebliche Übeltäter entlarven.
Staphylokokken
Kugelförmige Zellen mit einer Größe von 0,5 bis 1,5 μm, die in weintraubenähnlichen Haufen als Hautbakterien vorkommen. Ihr Temperaturoptimum liegt zwischen 30 und 37 Grad. Die Staphylokokken-Arten, die auf der menschlichen Haut und auf den Schleimhäuten vorkommen, haben in der Regel keine Krankheitsbedeutung und sind ungefährlich.

Corynebacterium
Diese keulenförmigen (griechisch coryne = Keule) Bakterien sind zwischen 3 und 5 μm lang. Bestimmte Vertreter der Gattung können, durch Bakteriophagen infiziert, Diphterie auslösen. Die Vertreter, die sich auf der menschlichen Haut und auf den Schleimhäuten befinden, sind in der Regel jedoch nicht krankheitserregend.

Die keimtötende Wirkung von Silber kannte man übrigens schon in der Antike. Heute wird Mikrosilber in Deos, Kosmetika und vor allem auch in Funktionsbekleidung eingesetzt. Die Silberionen dringen in die Bakterien ein, verändern deren Zellstoffwechsel und stoppen so ihre Vermehrung. Die Anwendung ist allerdings umstritten. Die Göteborger Umweltbehörde hat in einem Test neu gekaufte und zehnmal gewaschene Kleidungsstücke untersucht. Das Ergebnis: Alle Textilien geben in der Wäsche Silberionen ab, die so in den Wasserkreislauf gelangen können. Forschungsergebnisse des Hohenstein Instituts legen zumindest nahe, dass die Silberionen nicht der natürlichen Hautflora schaden, aber auch hier liefern andere Untersuchungen widersprüchliche Ergebnisse. Der Nutzen der Silberausrüstung für den sportlichen Gebrauch scheint den Forschern von Vermicon begrenzt zu sein. Offensichtlich schafft es das Produkt nicht, alle Bakterien zu “entschärfen”. Somit könne man auch auf die Ausrüstung verzichten, schließt Beimfohr aus dem Ergebnis.

Auch die Wirkungsweise der Merinowolle lässt sich mit unserem Laborversuch nicht sicher belegen. Auf der Probe des zehnmal gewaschenen Shirts wachsen ebenfalls Bakterienkolonien. Die Wirkung der Merinowolle liegt eher in ihrer Faserstruktur. Hierzu haben die Hohenstein-Wissenschaftler eine spannende Entdeckung gemacht: Wolle bindet die Geruchsmoleküle stärker und länger an sich als beispielsweise Polyester – und fängt daher auch erst später an zu stinken. Von den Kunstfasern können sich die Moleküle, die für den Geruch verantwortlich sind, scheinbar leichter lösen und in unsere Nasen vordringen.
Für welches Produkt man sich bei der Sportbekleidung letztlich entscheidet: Allein durch das Bekleidungsmaterial oder eine antimikrobiotische Ausrüstung, wie Silberionen oder Merino, wird man die Stinktierchen nicht los.
Silber vs. Merino gegen unangenehme Gerüche
Naturfaser oder chemische Keule – um Sportlern lästige Schweißgerüche in der Funktionsbekleidung zu ersparen, gehen die Hersteller unterschiedliche Wege. Das Ziel jedoch bleibt gleich: Die Bakterien sollen daran gehindert werden, den Schweiß zu zersetzen. So funktionieren die beiden Ansätze.
Silberionen
Um die Nano-Silberpartikel mit der Faser zu verbinden, gibt es zwei Methoden. Entweder wird das Nano-Silber in ein Polymer eingemischt und dann zu Fasern versponnen, oder es wird als Finish im Nachhinein auf die Faseroberfläche aufgebracht. Ersteres ergibt eine besonders feste Verbindung mit der Faser. In beiden Anwendungen wird die antimikrobielle Wirkung von Nano-Silber genutzt. Durch die Freisetzung von Silberionen (Ag+) werden beim Tragen der Bekleidung die Bakterien abgetötet. Die Silberionen dringen in die Bakterien, verändern deren Zellstoffwechsel und können so deren Vermehrung stoppen.
Merinofaser
Die Oberflächenstruktur der Fasern funktioniert wie Dachziegel. Dort finden die Bakterien nur wenig Halt und bleiben so vorwiegend auf der Haut. Weil Merinowolle schnell und viel Feuchtigkeit aufnimmt, bleibt den Bakterien nur wenig Zeit, den Schweiß zu zersetzen. Grundbaustein der Merinowolle ist das Eiweißmolekül Kreatin. Die Besonderheit daran: Diese Moleküle machen es den Bakterien besonders schwer, sich zu vermehren. Der Zersetzungsprozess von Schweiß wird so natürlich verzögert, und der unangenehme Geruch entsteht erst viel später (man spricht von einer Selbstreinigungsfunktion) als bei einer Kunstfaser.
Die Bakterien-Killer - das hilft gegen stinkende Sportbekleidung
Spezialwaschmittel, Chemie oder Kälte-Schock. Wir wollten wissen, welche Methode Bakterien am effektivsten aus der Bekleidung entfernt. Allerdings haben wir ja noch unsere Waschmittelproben in der Hinterhand. Und Achtung: Im Vergleich zu den ersten vier Proben sind die Testplättchen der Waschzusätze leergefegt wie die Straßen am Neujahrsmorgen. Bereits in der 40-Grad-Wäsche lösen Hygienespüler, Sportwaschmittel und Waschsoda nahezu alle Bakterien aus den Textilproben. Waschen hilft also! Trotzdem wird das Waschen bei niedrigen Temperaturen mit normalem Waschmittel nicht immer ausreichen, um Keime abzutöten, warnt die Expertin vom Hohenstein Institut. Je nach Textil kann sich obendrein ein unangenehmer Geruch in der Fahrradbekleidung festsetzen. Mit ein Grund, warum ältere Funktions-Shirts oft schon beim Reinschlüpfen ranzig riechen. Hier könnte es helfen, gelegentlich eine 60-Grad-Wäsche zu riskieren, rät Dr. Beimfohr und zerstört im selben Atemzug gleich noch einen alten Haushaltsmythos: Einfrieren könne man sich getrost sparen, schmunzelt die Forscherin. Sobald die Bakterien wieder aus ihrem Winterschlaf erwacht sind, futtern sie munter weiter und produzieren ihre übelriechenden Düfte.
Sollte der Klimawandel weiterhin so rasant fortschreiten und die Erde aufheizen, wird man im BIKE-Keller wohl bald an manchen Spinden nicht mehr vorbeigehen können, ohne eine Ohnmacht zu riskieren. Spätestens dann wird sich jedoch auch der letzte Kollege eingestehen müssen: Es ist wahr, wir haben tatsächlich ein Schweißproblem.

Vor der Wäsche wachsen zahlreiche Bakterienkolonien (gelb) auf dem Polyester-Shirt. Proben aus diesem Textil haben wir vier verschiedenen Anwendungen unterzogen. Am Ende sollten keine Bakterien mehr auf dem Nährmedium wachsen.
Hygienespüler
Sagrotan ist in unserem Vergleich das wirksamste Mittel gegen die Bakterien. Im Test entfernt der Hygienespüler nahezu rückstandslos alle Mikroben. Er wirkt wie ein Desinfektionsmittel, bricht die Zellwände auf und zerstört so die Bakterienzellen. Fraglich ist allerdings noch, ob und wie schädlich Sagrotan für die Fasern der Funktionsbekleidung und als Rückstand im Abwasser ist.

Sportwaschmittel
Im Test arbeitet das Textile Wash von Holmenkol ähnlich gut wie Sagrotan. Aufgrund der enthaltenen Stoffe wirkt das Sportwaschmittel wie eine Chlor-Essig-Behandlung, also ähnlich einem Säurebad, in dem die Bakterien abgetötet werden. Auf der Agarplatte (Nährmedium) sind nur noch geringe Bakterienrückstände zu sehen, erkennbar an den beiden gelben Pünktchen am Probenrand.

Waschsoda
Im Wasser gelöst ist Waschsoda stark alkalisch und löst auch hartnäckigen Schmutz und Fette. Im Test zeigt das Produkt von Holste im Vergleich mit den beiden anderen Waschmitteln eine gute, aber geringere Wirkung. Auf dem Nährmedium lassen sich noch einige Bakterienkulturen nachweisen. Für Textilien aus tierischen Fasern ist Soda übrigens nicht geeignet, da es die Fasern zum Aufquellen bringt.

Einfrieren von Sportbekleidung
Das beliebte Hausmittel ist ein Mythos. Die Bakterien fallen bei -20 Grad quasi in den Winterschlaf. Sobald die Temperatur wieder steigt und Nährstoffe vorhanden sind, nehmen die Bakterien ihre Arbeit wieder auf und verstoffwechseln den Schweiß. Vermutlich sterben zwar auch einige Bakterien ab, weil ihre Zellwände zerstört werden. Der Großteil überlebt jedoch. Zudem bleiben die Bakterien im Stoff der Sportbekleidung, weil sie nicht wie bei den anderen Methoden mechanisch aus der Faser ausgewaschen werden.

Nie wieder stinken? Mit diesen Tricks entstehen Gerüche gar nicht erst in der Fahrradbekleidung
Auch wenn es die Werbung vielleicht verspricht, noch gibt es keine absolut geruchsresistenten Funktionstextilien. Wir haben dennoch ein paar Tipps, wie sie in Zukunft die dicke Luft im Spind etwas verdünnen können und Gerüche in der Fahrradbekleidung mindern.
1. Trikots trocknen
Hängen Sie Ihre Fahrradbekleidung direkt nach der Fahrt zum Trocknen auf. Hautbakterien lieben warme und feuchte Verhältnisse und gedeihen so besonders gut. Wenn Sie Ihre Klamotten also erst mal feucht auf einem Haufen liegen lassen, ist der Gestank quasi vorprogrammiert. Auch Kälte hilft. Bakterien arbeiten nur bei ihrem Temperaturoptimum auf Hochtouren. Allerdings wird das Wachstum der Bakterien so nur verzögert.
2. Nach jeder Ausfahrt waschen
Vor allem Sportbekleidung aus Kunstfasern sollten Sie nach jedem Mal Tragen in die Wäsche geben. Ziehen Sie ein bereits getragenes Teil bei der nächsten Ausfahrt wieder an, wird den Bakterien ihre Nahrungsgrundlage förmlich auf dem Silbertablett serviert, und sie können direkt damit fortfahren, die bereits vorhandenen Schweißmoleküle zu zersetzen.
3. Auf Risiko waschen
Hautbakterien sind hitzeresistent und bei 40 Grad nicht kaputtzukriegen. Auch wenn das Pflegeetikett nur eine 40-Grad-Wäsche erlaubt, empfiehlt Craft zum Beispiel jedes dritte Mal bei 60 Grad zu waschen. Ausnahme: Teile mit Elastan-Anteil dürfen nicht in die Kochwäsche, weil sich diese Fasern bei Hitze zusammenziehen und so das Bekleidungsstück zerstört wird. Die Alternative: Es gibt Fahrradbekleidung, die von Haus aus auch bei 60 Grad gewaschen werden darf. Achten Sie beim Kauf also immer auf die Anweisung im Etikett.

4. Rasieren
Das feuchtwarme Klima unter den Achseln ist eine Wohlfühloase für Hautbakterien. Dort sitzen sie auf den Achselhaaren wie die Hühner auf der Stange. Wer sich rasiert, wird zwar nicht bakterienlos durchs Leben streifen, was auch gar nicht gewünscht ist. Allerdings können es sich die winzigen Schweißfresser so nur deutlich schwerer bequem machen, weil ganz einfach weniger Platz zur Verfügung steht.
5. Regelmäßig austauschen
Das Problem kennt jeder: Irgendwann kommt der Zeitpunkt, an dem das Unterhemd allein schon beim Anziehen müffelt. Geruchsmoleküle können sich sehr hartnäckig in den Textilfasern festsetzen, sodass sie auch in der Waschmaschine nicht vollständig entfernt werden. Mit der Zeit sammeln sich immer mehr dieser Geruchsmoleküle im Kleidungsstück und sorgen für einen dauerhaft unangenehmen Mief. Jetzt hilft nur noch eins: Das alte Teil muss aussortiert und durch ein neues ersetzt werden.
Interview mit Guido Augustiniak, Geschäftsführer von Fibertec
Fibertec ist ein Hersteller von Imprägnier- und Pflegeprodukten, der Geschäftsführer Guido Augustiniak sagte uns im Interview:
Aktivkohle-Fasern aus Kokosnussschalen wären eine ideale Alternative zu chemischen Ausrüstungen – Guido Augustiniak, Geschäftsführer von Fibertec
BIKE: Wieso raten Sie von Silberzusätzen in Bekleidung und Waschzusätzen ab?
Guido Augustiniak: Silberionen funktionieren an sich super. Leider unterscheiden sie nicht zwischen "guten" und "schlechten" Bakterien. Sie töten bei Kontakt schlicht alle Bakterien ab und können so unsere sensible Hautflora stören, die ja ein wichtiger Teil unseres Immunsystems ist.
Gibt es noch andere Probleme?
Über die Wäsche gelangen die Silberionen ins Abwasser und so in die Kläranlagen. Dort zerstören sie auch die Bakterien, die eigentlich unser Wasser reinigen sollen, beispielsweise von Fäkalien. Die Folge: Es besteht die Gefahr, dass sich resistente Bakterienstämme bilden. Dieses Phänomen gibt es ja bereits bei Antibiotika, was schon heute in Krankenhäusern Probleme macht.
Was sind die Alternativen?
Wir arbeiten an einem Waschmittel, das auf Enzym-Ebene arbeitet und eine biologische Reaktion hervorruft. Die Wirkung basiert auf den Van-der-Waals-Kräften und wandelt stinkende Substanzen in geruchsneutrale Salze um. Aktuell setzen wir das schon in einem Schuh-Deo ein.
Welche Alternativen gibt es denn schon heute?
Naturfasern wie Merinowolle zum Beispiel. Die riechen von Haus aus nicht so stark. Leider ist Merinowäsche weniger gut für intensive Aktivitäten geeignet, weil sie sehr viel Schweiß aufnimmt. Es gibt auch Funktionswäsche, die man bei 60 Grad waschen kann. So werden die Bakterien beim Waschen abgetötet, und man kann getrost auf chemische Zusätze oder Ausrüstungen verzichten. Schweiß an sich stinkt ja nicht. Der Geruch entsteht erst, wenn die Bakterien den Schweiß zersetzen.
Wozu brauche ich dann überhaupt ein Waschmittel?
Ein gutes, ökologisches Waschmittel ist die Basis. Es löst nicht nur Schmutz, sondern auch die geruchsbildenden Bakterien. Von Hygienespülern wie Sagrotan rate ich übrigens ab. Die sind genauso aggressiv wie Silberionen und töten unspezifisch alle Bakterien ab.
Gibt es außer Merino noch andere Naturfasern?
Ja, die sogenannte Cocona-Faser basiert auf Aktivkohle aus recycelten Kokosnuss-Schalen. Das Tolle daran: Im Gegensatz zu Merinowolle trocknet die Faser genauso schnell wie Kunstfaser. Trotzdem riecht die Wäsche auch nach mehrmaligem Tragen nicht unangenehm. Leider wird die Faser aktuell nur von sehr wenigen Herstellern eingesetzt. Sie wäre eine super Alternative für Sportler, die bei hoher Intensität viel schwitzen.


Stefan Frey
Redakteur

Diskutieren Sie mit – fair, sachlich und respektvoll. Es gilt unsere Netiquette.